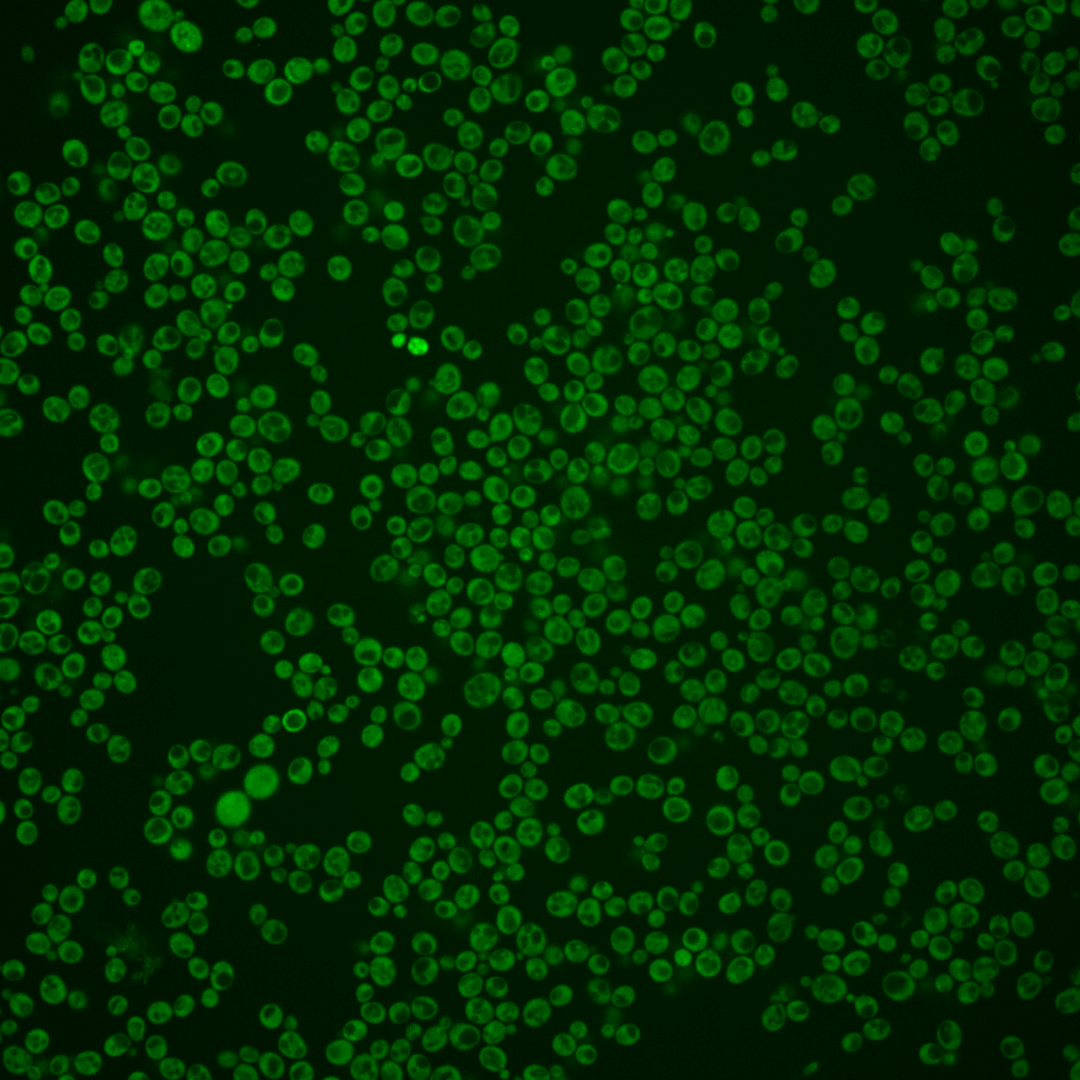
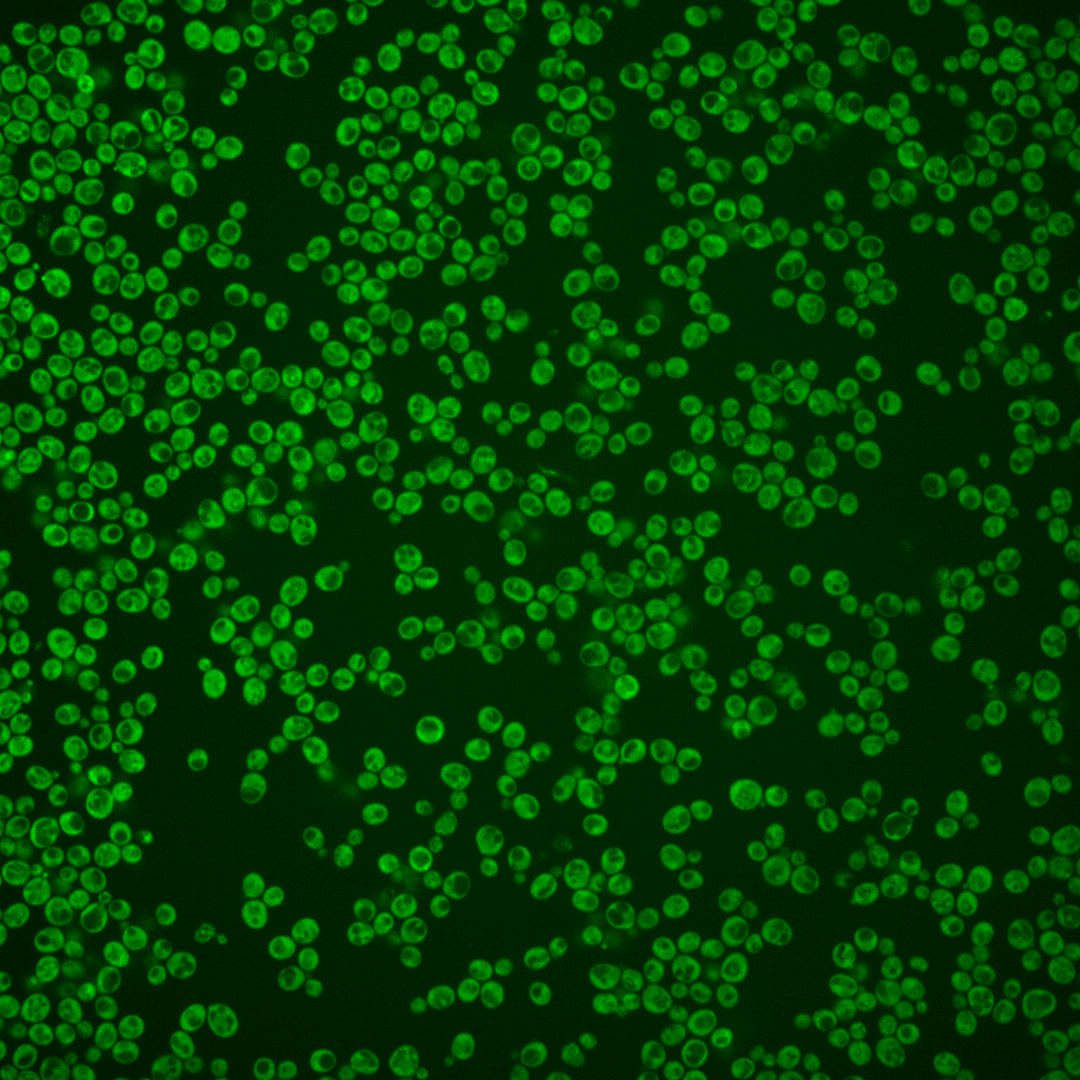
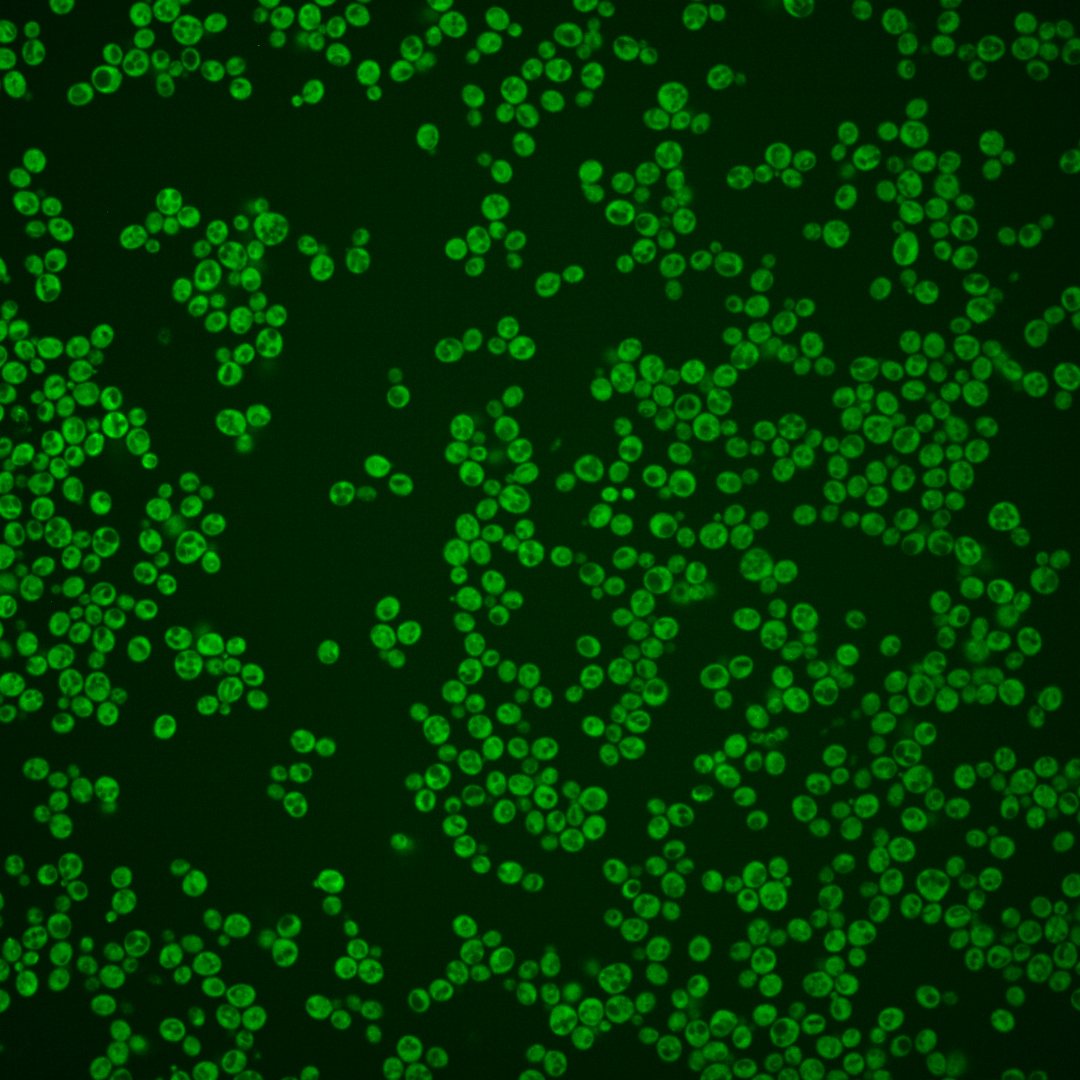
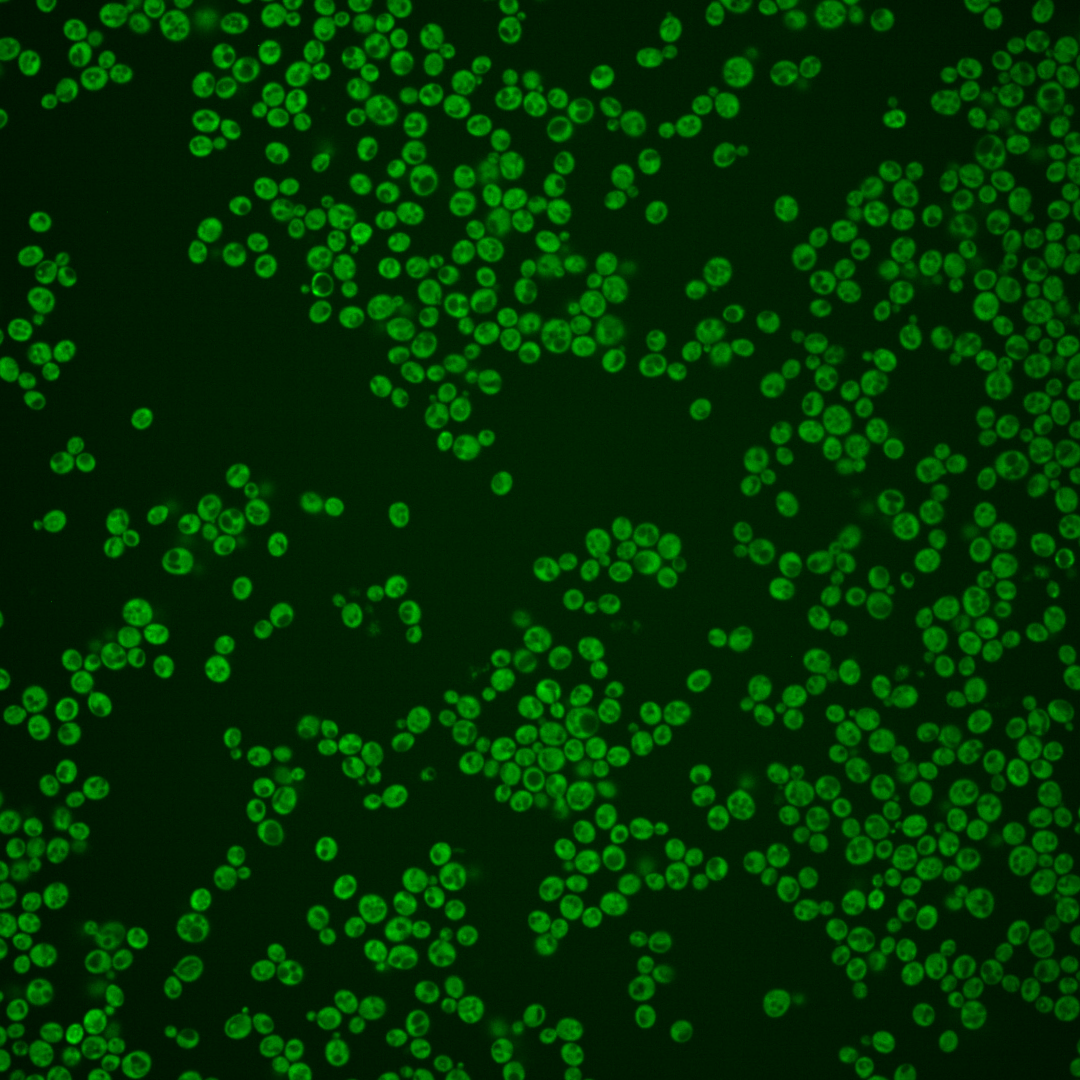
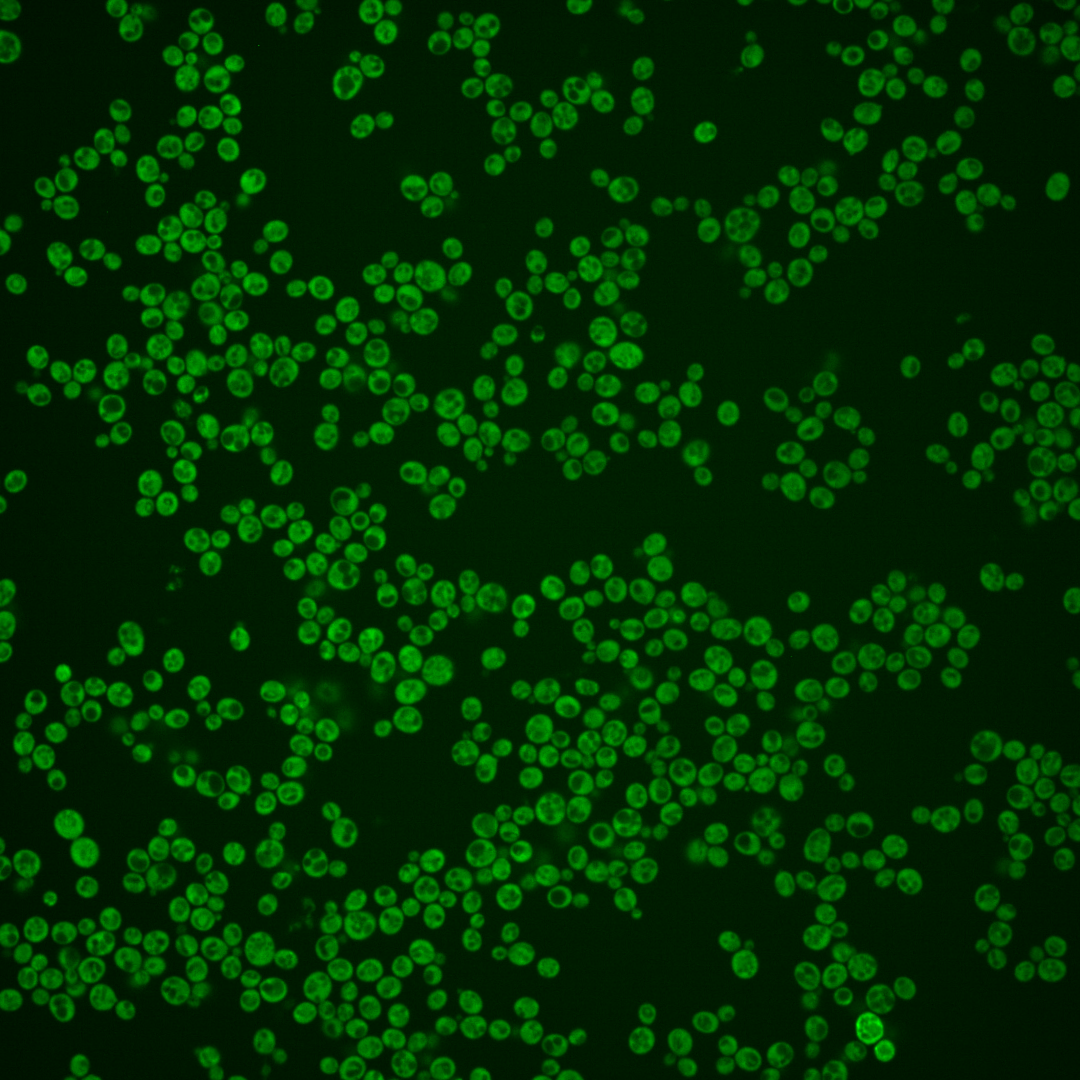

| Standard name | |
|---|---|
| Human Ortholog | |
| Description | Ski complex component and putative RNA helicase; mediates 3'-5' RNA degradation by the cytoplasmic exosome; null mutants have superkiller phenotype of increased viral dsRNAs and are synthetic lethal with mutations in 5'-3' mRNA decay; mutations in the human ortholog, SKIV2L, causes Syndromic diarrhea/Trichohepatoenteric (SD/THE) syndrome |
Micrographs




















































































Sub-cellular Localization
Yeast GFP Assignment
Protein Abundance
Localization Change
External localization resources
| ensLOC | DeepLoc | |||||||||||||||||||||||
|---|---|---|---|---|---|---|---|---|---|---|---|---|---|---|---|---|---|---|---|---|---|---|---|---|
| Localization | WT1 | WT2 | WT3 | RAP60 | RAP140 | RAP220 | RAP300 | RAP380 | RAP460 | RAP540 | RAP620 | RAP700 | HU80 | HU120 | HU160 | rpd3Δ_1 | rpd3Δ_2 | rpd3Δ_3 | WT1 | WT2 | WT3 | AF100 | AF140 | AF180 |
| Cortical Patches | 1 | 2 | 2 | 0 | 3 | 7 | 3 | 4 | 2 | – | 4 | 5 | 3 | 2 | 1 | 3 | 1 | 3 | 0 | 0 | 2 | 0 | 0 | 1 |
| Bud | 0 | 2 | 6 | 1 | 2 | 5 | 5 | 5 | 6 | – | 7 | 8 | 1 | 0 | 3 | 0 | 0 | 0 | 0 | 0 | 0 | 0 | 0 | 1 |
| Bud Neck | 0 | 0 | 0 | 0 | 0 | 0 | 0 | 0 | 0 | – | 0 | 0 | 0 | 0 | 0 | 0 | 0 | 0 | 0 | 1 | 0 | 0 | 0 | 0 |
| Bud Site | 0 | 0 | 0 | 0 | 0 | 0 | 0 | 0 | 0 | – | 0 | 0 | 0 | 0 | 0 | 0 | 0 | 0 | – | – | – | – | – | – |
| Cell Periphery | 26 | 6 | 10 | 3 | 14 | 8 | 16 | 6 | 14 | – | 16 | 28 | 1 | 12 | 6 | 5 | 7 | 11 | 0 | 0 | 0 | 0 | 0 | 0 |
| Cytoplasm | 458 | 370 | 331 | 279 | 286 | 369 | 346 | 375 | 251 | – | 243 | 296 | 188 | 245 | 273 | 274 | 168 | 200 | 519 | 369 | 331 | 151 | 180 | 172 |
| Endoplasmic Reticulum | 18 | 14 | 12 | 9 | 13 | 14 | 19 | 20 | 15 | – | 24 | 27 | 5 | 3 | 2 | 16 | 9 | 9 | 12 | 7 | 15 | 12 | 12 | 31 |
| Endosome | 1 | 0 | 0 | 0 | 0 | 0 | 2 | 1 | 0 | – | 0 | 0 | 3 | 1 | 0 | 5 | 1 | 1 | 2 | 0 | 1 | 0 | 1 | 2 |
| Golgi | 3 | 1 | 1 | 0 | 0 | 0 | 0 | 0 | 0 | – | 0 | 0 | 0 | 0 | 1 | 3 | 3 | 2 | 0 | 0 | 2 | 0 | 1 | 1 |
| Mitochondria | 5 | 0 | 9 | 35 | 49 | 117 | 161 | 176 | 199 | – | 239 | 307 | 3 | 4 | 27 | 6 | 1 | 3 | 8 | 1 | 9 | 2 | 1 | 1 |
| Nucleus | 2 | 1 | 1 | 0 | 0 | 0 | 2 | 2 | 1 | – | 0 | 3 | 0 | 2 | 0 | 5 | 3 | 3 | 2 | 4 | 1 | 0 | 0 | 0 |
| Nuclear Periphery | 0 | 2 | 0 | 0 | 0 | 0 | 1 | 0 | 0 | – | 0 | 1 | 0 | 0 | 1 | 1 | 0 | 0 | 3 | 0 | 0 | 0 | 0 | 1 |
| Nucleolus | 1 | 0 | 0 | 0 | 0 | 0 | 0 | 0 | 0 | – | 0 | 0 | 0 | 0 | 1 | 0 | 1 | 0 | 0 | 0 | 0 | 0 | 0 | 0 |
| Peroxisomes | 0 | 0 | 0 | 0 | 0 | 0 | 0 | 0 | 0 | – | 0 | 0 | 0 | 0 | 0 | 0 | 0 | 0 | 0 | 0 | 0 | 0 | 0 | 0 |
| SpindlePole | 0 | 0 | 0 | 0 | 0 | 0 | 0 | 0 | 0 | – | 0 | 0 | 0 | 0 | 0 | 0 | 1 | 1 | 0 | 0 | 0 | 0 | 0 | 0 |
| Vac/Vac Membrane | 17 | 4 | 6 | 0 | 8 | 5 | 8 | 13 | 14 | – | 9 | 16 | 6 | 2 | 0 | 32 | 25 | 34 | 17 | 10 | 10 | 3 | 5 | 5 |
| Unique Cell Count | 504 | 385 | 355 | 297 | 336 | 451 | 481 | 532 | 412 | 430 | 546 | 202 | 254 | 281 | 326 | 195 | 237 | 569 | 399 | 382 | 174 | 208 | 224 | |
| Labelled Cell Count | 532 | 402 | 378 | 327 | 375 | 525 | 563 | 602 | 502 | 542 | 691 | 210 | 271 | 315 | 350 | 220 | 267 | 569 | 399 | 382 | 174 | 208 | 224 | |
Yeast GFP Assignment
Protein Abundance
| Screen | WT1 | WT2 | WT3 | RAP60 | RAP140 | RAP220 | RAP300 | RAP380 | RAP460 | RAP540 | RAP620 | RAP700 | HU80 | HU120 | HU160 | rpd3Δ_1 | rpd3Δ_2 | rpd3Δ_3 | AF100 | AF140 | AF180 |
|---|---|---|---|---|---|---|---|---|---|---|---|---|---|---|---|---|---|---|---|---|---|
| Mean Cell GFP Intensity (1e-4) | 14.6 | 11.6 | 8.4 | 7.7 | 8.0 | 7.2 | 6.9 | 6.4 | 6.1 | – | 5.8 | 5.6 | 9.9 | 9.7 | 8.9 | 11.5 | 12.9 | 12.1 | 10.9 | 11.9 | 12.3 |
| Std Deviation (1e-4) | 4.5 | 1.9 | 1.3 | 1.1 | 1.4 | 1.1 | 1.3 | 1.1 | 1.3 | – | 1.2 | 1.1 | 1.5 | 1.5 | 1.4 | 2.8 | 3.0 | 3.2 | 1.8 | 2.1 | 2.2 |
| Intensity Change (Log2) | – | – | – | -0.13 | -0.07 | -0.21 | -0.28 | -0.39 | -0.46 | – | -0.52 | -0.59 | 0.24 | 0.2 | 0.08 | 0.46 | 0.63 | 0.53 | 0.38 | 0.51 | 0.55 |
Localization Change
| Localization | RAP60 | RAP140 | RAP220 | RAP300 | RAP380 | RAP460 | RAP540 | RAP620 | RAP700 | HU80 | HU120 | HU160 | rpd3Δ_1 | rpd3Δ_2 | rpd3Δ_3 |
|---|---|---|---|---|---|---|---|---|---|---|---|---|---|---|---|
| Cortical Patches | 0 | 0 | 0 | 0 | 0 | 0 | – | 0 | 0 | 0 | 0 | 0 | 0 | 0 | 0 |
| Bud | 0 | 0 | 0 | 0 | 0 | -0.3 | – | -0.1 | -0.3 | 0 | 0 | 0 | 0 | 0 | 0 |
| Bud Neck | 0 | 0 | 0 | 0 | 0 | 0 | – | 0 | 0 | 0 | 0 | 0 | 0 | 0 | 0 |
| Bud Site | 0 | 0 | 0 | 0 | 0 | 0 | – | 0 | 0 | 0 | 0 | 0 | 0 | 0 | 0 |
| Cell Periphery | -1.6 | 1.0 | -1.0 | 0.4 | -1.9 | 0.5 | – | 0.7 | 1.7 | 0 | 1.2 | -0.5 | -1.1 | 0.5 | 1.2 |
| Cytoplasm | 0.4 | -3.5 | -4.8 | -7.8 | -8.2 | -10.4 | – | -11.6 | -12.4 | -0.1 | 1.7 | 2.2 | -3.8 | -2.7 | -3.5 |
| Endoplasmic Reticulum | -0.3 | 0.3 | -0.2 | 0.4 | 0.3 | 0.2 | – | 1.5 | 1.1 | -0.6 | -1.7 | -2.3 | 1.0 | 0.7 | 0.3 |
| Endosome | 0 | 0 | 0 | 0 | 0 | 0 | – | 0 | 0 | 0 | 0 | 0 | 0 | 0 | 0 |
| Golgi | 0 | 0 | 0 | 0 | 0 | 0 | – | 0 | 0 | 0 | 0 | 0 | 0 | 0 | 0 |
| Mitochondria | 4.7 | 5.7 | 9.1 | 11.0 | 11.0 | 14.2 | – | 15.9 | 16.5 | 0 | -0.8 | 3.8 | -0.6 | 0 | 0 |
| Nucleus | 0 | 0 | 0 | 0 | 0 | 0 | – | 0 | 0 | 0 | 0 | 0 | 0 | 0 | 0 |
| Nuclear Periphery | 0 | 0 | 0 | 0 | 0 | 0 | – | 0 | 0 | 0 | 0 | 0 | 0 | 0 | 0 |
| Nucleolus | 0 | 0 | 0 | 0 | 0 | 0 | – | 0 | 0 | 0 | 0 | 0 | 0 | 0 | 0 |
| Peroxisomes | 0 | 0 | 0 | 0 | 0 | 0 | – | 0 | 0 | 0 | 0 | 0 | 0 | 0 | 0 |
| SpindlePole | 0 | 0 | 0 | 0 | 0 | 0 | – | 0 | 0 | 0 | 0 | 0 | 0 | 0 | 0 |
| Vacuole | 0 | 0.6 | 0 | 0 | 0.8 | 1.5 | – | 0.4 | 1.2 | 0 | 0 | 0 | 4.6 | 5.4 | 6.0 |
External localization resources
Images






























Protein Concentration and Protein Localization Data
| R1 | R2 | R3 | ||||||||||||||||
|---|---|---|---|---|---|---|---|---|---|---|---|---|---|---|---|---|---|---|
| G1 Pre-START | G1 Post-START | S/G2 | Metaphase | Anaphase | Telophase | G1 Pre-START | G1 Post-START | S/G2 | Metaphase | Anaphase | Telophase | G1 Pre-START | G1 Post-START | S/G2 | Metaphase | Anaphase | Telophase | |
| Concentration | 10.7253 | 13.9374 | 12.5071 | 11.1939 | 11.6014 | 12.3356 | 9.5185 | 12.4463 | 11.1359 | 10.5066 | 10.0554 | 11.2516 | 11.1996 | 12.6508 | 11.9623 | 11.577 | 11.0361 | 12.0383 |
| Actin | 0.001 | 0.001 | 0.0009 | 0.0023 | 0.0011 | 0.001 | 0.0021 | 0.0002 | 0.0016 | 0.0003 | 0.0001 | 0.0004 | 0.0013 | 0.0024 | 0.001 | 0.0009 | 0.0002 | 0.0009 |
| Bud | 0.0011 | 0.0007 | 0.0013 | 0.0022 | 0.0006 | 0.0008 | 0.0004 | 0.0004 | 0.0006 | 0.0006 | 0.0003 | 0.0002 | 0.0005 | 0.0007 | 0.0006 | 0.0005 | 0.0004 | 0.0005 |
| Bud Neck | 0.0011 | 0.0008 | 0.0012 | 0.0014 | 0.0016 | 0.0033 | 0.0004 | 0.0002 | 0.0004 | 0.0006 | 0.0004 | 0.0011 | 0.0004 | 0.0004 | 0.0005 | 0.0006 | 0.0006 | 0.0012 |
| Bud Periphery | 0.0022 | 0.0008 | 0.0015 | 0.0048 | 0.0005 | 0.0017 | 0.0003 | 0.0002 | 0.0004 | 0.0003 | 0.0002 | 0.0001 | 0.0004 | 0.0002 | 0.0004 | 0.0003 | 0.0001 | 0.0005 |
| Bud Site | 0.0009 | 0.0014 | 0.0016 | 0.0011 | 0.0003 | 0.0003 | 0.0005 | 0.0004 | 0.0006 | 0.0004 | 0.0001 | 0.0001 | 0.0007 | 0.0018 | 0.0006 | 0.0003 | 0.0002 | 0.0002 |
| Cell Periphery | 0.0035 | 0.002 | 0.0018 | 0.0042 | 0.0005 | 0.0024 | 0.0004 | 0.0001 | 0.0002 | 0.0001 | 0.0001 | 0.0001 | 0.0009 | 0.0003 | 0.0003 | 0.0002 | 0 | 0.0003 |
| Cytoplasm | 0.7853 | 0.9037 | 0.8294 | 0.7871 | 0.8287 | 0.8349 | 0.8521 | 0.9576 | 0.9025 | 0.8631 | 0.8714 | 0.8865 | 0.8434 | 0.9118 | 0.8834 | 0.8079 | 0.9048 | 0.8635 |
| Cytoplasmic Foci | 0.008 | 0.0064 | 0.0072 | 0.013 | 0.0117 | 0.0102 | 0.0204 | 0.0086 | 0.0173 | 0.0218 | 0.0163 | 0.0184 | 0.0172 | 0.0178 | 0.0152 | 0.0168 | 0.0199 | 0.0215 |
| Eisosomes | 0 | 0 | 0 | 0 | 0 | 0 | 0 | 0 | 0 | 0 | 0 | 0 | 0 | 0 | 0 | 0 | 0 | 0 |
| Endoplasmic Reticulum | 0.0982 | 0.0435 | 0.0724 | 0.0321 | 0.0832 | 0.0846 | 0.0434 | 0.0069 | 0.0099 | 0.0076 | 0.0188 | 0.0272 | 0.0521 | 0.0161 | 0.0193 | 0.0347 | 0.0034 | 0.0267 |
| Endosome | 0.0324 | 0.0165 | 0.0313 | 0.0669 | 0.0398 | 0.0274 | 0.0478 | 0.0153 | 0.044 | 0.08 | 0.0697 | 0.0473 | 0.0543 | 0.0301 | 0.0523 | 0.0822 | 0.0576 | 0.0549 |
| Golgi | 0.0065 | 0.0032 | 0.0036 | 0.0085 | 0.0061 | 0.0048 | 0.008 | 0.0022 | 0.0043 | 0.0036 | 0.0034 | 0.0073 | 0.0093 | 0.0079 | 0.005 | 0.0106 | 0.0033 | 0.0127 |
| Lipid Particles | 0.0008 | 0.0002 | 0.0004 | 0.0002 | 0.0003 | 0.0002 | 0.0034 | 0 | 0.0004 | 0 | 0 | 0 | 0.0003 | 0.0002 | 0.0002 | 0.0002 | 0 | 0.0001 |
| Mitochondria | 0.0136 | 0.0029 | 0.0047 | 0.0044 | 0.0036 | 0.012 | 0.0058 | 0.0028 | 0.0024 | 0.0021 | 0.0023 | 0.0051 | 0.0051 | 0.0025 | 0.0033 | 0.0037 | 0.0014 | 0.0099 |
| None | 0.0087 | 0.0007 | 0.0007 | 0.0007 | 0.0007 | 0.0008 | 0.003 | 0.0008 | 0.0014 | 0.0012 | 0.0015 | 0.001 | 0.0017 | 0.0009 | 0.0007 | 0.0006 | 0.0005 | 0.0008 |
| Nuclear Periphery | 0.0041 | 0.0015 | 0.0045 | 0.0043 | 0.0034 | 0.002 | 0.0021 | 0.0004 | 0.0009 | 0.0012 | 0.002 | 0.0006 | 0.0016 | 0.0008 | 0.0014 | 0.0017 | 0.0005 | 0.0007 |
| Nucleolus | 0.0001 | 0 | 0 | 0.0001 | 0 | 0 | 0 | 0 | 0 | 0 | 0 | 0 | 0 | 0 | 0 | 0 | 0 | 0 |
| Nucleus | 0.002 | 0.0013 | 0.0021 | 0.0024 | 0.0015 | 0.0013 | 0.001 | 0.0005 | 0.001 | 0.001 | 0.0012 | 0.0007 | 0.0008 | 0.0008 | 0.0009 | 0.0008 | 0.0007 | 0.0007 |
| Peroxisomes | 0.0001 | 0.0001 | 0.0001 | 0.0001 | 0.0001 | 0.0001 | 0.001 | 0 | 0.0019 | 0.0001 | 0 | 0.0001 | 0.0001 | 0.0001 | 0.0001 | 0.0001 | 0.0001 | 0.0001 |
| Punctate Nuclear | 0.0001 | 0 | 0.0001 | 0.0001 | 0.0001 | 0.0001 | 0.0005 | 0 | 0.0001 | 0.0001 | 0.0001 | 0.0001 | 0.0001 | 0.0001 | 0.0001 | 0.0001 | 0 | 0.0001 |
| Vacuole | 0.0255 | 0.0115 | 0.0295 | 0.0516 | 0.013 | 0.0089 | 0.0058 | 0.0025 | 0.0081 | 0.0115 | 0.0082 | 0.0025 | 0.0078 | 0.0042 | 0.0114 | 0.0335 | 0.0045 | 0.0032 |
| Vacuole Periphery | 0.0047 | 0.0019 | 0.0057 | 0.0127 | 0.0031 | 0.0032 | 0.0016 | 0.0006 | 0.0019 | 0.0044 | 0.0038 | 0.0012 | 0.0021 | 0.001 | 0.0033 | 0.004 | 0.0018 | 0.0016 |
Sequencing Data
| R1 | R2 | |||||||||
|---|---|---|---|---|---|---|---|---|---|---|
| G1 Post-START | S/G2 | Metaphase | Anaphase | Telophase | G1 Post-START | S/G2 | Metaphase | Anaphase | Telophase | |
| Gene Expression | 29.1271 | 27.3142 | 33.9069 | 37.482 | 25.3615 | 25.1154 | 31.8762 | 34.4054 | 39.1013 | 34.6752 |
| Translational Efficiency | 1.5402 | 1.3103 | 1.1063 | 1.2249 | 1.2374 | 1.4417 | 1.087 | 0.8938 | 0.8978 | 0.9892 |
Hit Data
| Dataset | Hit |
|---|---|
| Protein Concentration | ✘ |
| Protein Localization | ✘ |
| Gene Expression | ✔ |
| Translational Efficiency | ✘ |
Endocytosis
| Temp | Actin Patch (Sac6-tdTomato) | Cortical Patch (Sla1-GFP) | Late Endosome (Snf7-GFP) | Vacuole (Vph1-GFP) |
|---|---|---|---|---|
| 37℃ | ||||
| RT |
Cell Cycle Omics
CYCLoPs (Ski2-GFP)
| Gene / Allele | Actin Patch (Sac6-tdTomato) | Cortical Patch (Sla1-GFP) | Late Endosome (Snf7-GFP) | Vacuole (Sac6-tdTomato) |
|---|
| Gene | Images |
|---|
| Gene | Images |
|---|
Images are not yet available
Images are not yet available